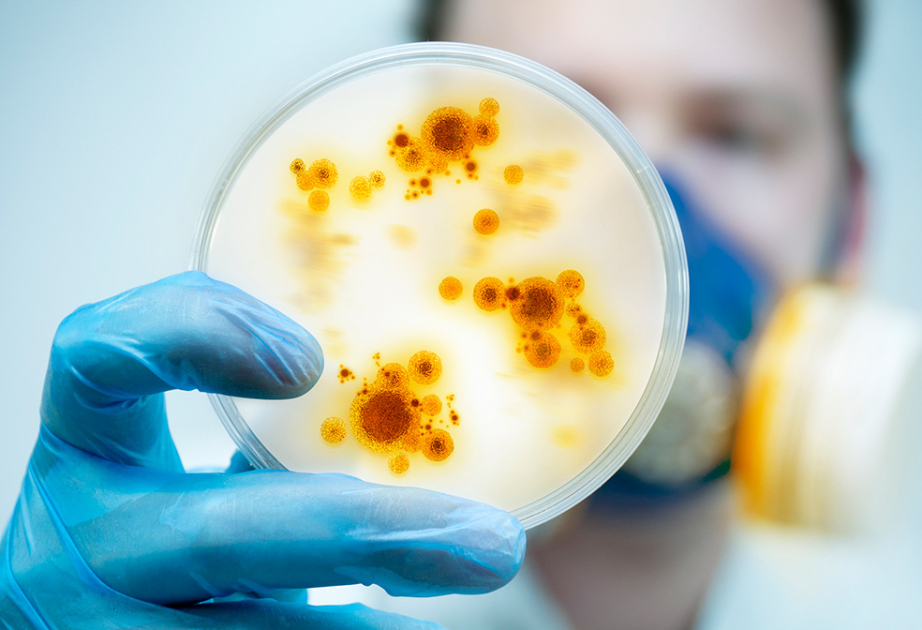

Read the latest news from regional and global sources, presenting different voices and perspectives.

Vietnamese-Danish jazz artist Niels Lan Doky will perform in Ho Chi Minh City on 15 November
ShareSharePin ItShare Niels Lan Doky will perform at jazz concert to Ho Chi Minh City’s Gem Centre on 15 November. Photo: Facebook. Vietnamese-Danish jazz artist Niels Lan Doky (Đỗ Kỳ Lân) will perform the concert Immersed at Gem Centre in Ho Chi...
Vietnam plans to train energy engineers to achieve energy security
HANOI, Oct. 16 (Xinhua) -- Vietnam aims to train between 25,000 and 35,000 engineers and experts in the energy sector, with a particular focus on nuclear energy, Vietnam News Agency reported Thursday. The move is part of the government's action...

UAE group to build $2-billion AI super data centre in Ho Chi Minh City
The closing session of the first Congress of the Ho Chi Minh City Party Organisation for the 2025-2030 term took place on October 15. During the session, Lam Dinh Thang, director of the Department of Science and Technology, stated that science,...

Vietnam ETFs: An Emerging Opportunity
Last week FTSE made its annual review of country classification within its global equity indices (see the announcement here). One of the most interesting changes was Vietnam’s upgrade from frontier to emerging market. This will affect all FTSE...
Vietnamese cuisine ranks among world’s most alluring in 2025

Vietnam Sets Goal to Reach $8,500 Per Capita GDP by 2030
In preparation for the Party's 14th National Congress, the Central Commission for Communication and Education and pertinent agencies announced the draft political documents for public consultation at a press conference on Wednesday, October 15. A...
Vietnam weighs establishment of gold exchange to ensure market stability

New Vietnam Airline bets tourism boom can offset crowded skies
HANOI — Startup Vietnamese carrier Sun PhuQuoc Airways plans to acquire a total of 100 Airbus SE and Boeing Co jets within five years as it seeks to break into the country’s fast expanding tourism market and crack the nation’s congested skies. The...

Vietnam proposes financial support for residential solar, storage systems
Households in Vietnam could receive up to VND 3 million ($113.9) in investment capital for home solar-plus-storage systems installed for self-consumption, or a preferential loan of up to VND 40 million, under proposals from the country’s Ministry...

Africa emerges as new market for Vietnamese rice
Vietnam's rice industry is facing one of its toughest challenges in years as two major markets, the Philippines and Indonesia, have sharply cut imports, forcing exporters to scramble for alternative buyers. Many firms are now pivoting to Africa,...

Business News | A Conglomerate's Strategy to Keep Vietnam's Growth in Its Own Hands
NewsVoir Gurugram (Haryana) [India], October 16: When Vingroup, the largest private conglomerate in Vietnam, launched VinMetal in September 2025, it made clear that this was about more than steel. The company is investing about 380 million dollars...

Relazioni diplomatiche Germania – Vietnam tra vergogne tedesco – occidentali da nascondere e meriti tedesco – orientali dimenticati
Nel settembre 2025 la Germania ha celebrato con discorsi ufficiali del tutto superficiali e passaggi mediatici modesti il cinquantennale delle relazioni diplomatiche con la Repubblica Socialista del Vietnam, tuttavia la storia è ben più complessa...

EU-Vietnam relations need speed and trust to reach next level, says MEP Lange
With its rapid growth, digital ambition, and expanding global reach, Vietnam is emerging as one of Asia’s most dynamic economies – an increasingly attractive partner for the European Union, both economically and geopolitically. In this exclusive...

Korean, Vietnamese cast and crew of 'Leaving Mom' to hold special press, fan event at CGV Yongsan
Published: 16 Oct. 2025, 15:52 Updated: 16 Oct. 2025, 19:55 ″Leaving Mom″ film poster [SIDUS] The cast and crew of film "Leaving Mom," a 3-year collaborative effort between Vietnamese and Korean producers, will visit Korea to talk with local...

Singapore Red Cross to contribute S$50,000 to support flood relief efforts in Vietnam
SINGAPORE: The Singapore Red Cross (SRC) will intensify humanitarian efforts following a series of natural disasters in Vietnam and the Philippines. The SRC will contribute S$50,000 (US$38,600) to the Viet Nam Red Cross to support immediate relief...
Vietnam, China, Laos conduct cross-border infectious disease emergency response drill
Baku, October 16, AZERTAC A joint emergency response drill for cross-border infectious diseases was held in Jiangcheng county, Pu'er city, China’s Yunnan province from October 14 to 15 as part of the Vietnam-China-Laos Cross-Border Infectious...

China, Laos, and Vietnam ramp up collaboration regarding cross-border infectious diseases
A joint emergency drill for the prevention and control of cross-border infectious diseases is held on Oct 15 in Jiangcheng county, Yunnan province. [Photo provided to chinadaily.com.cn] On Wednesday, officials and experts from China, Laos, and...

La Plata Police Join Legion Riders To Honor Vietnam Veteran
Photo Credit: La Plata Police Department Facebook LA PLATA, Md. — On Friday, Oct. 10, personnel from the La Plata Police Department and members of American Legion Post 82’s Legion Riders made a special visit to honor U.S. Marine Corps veteran...
World : Vietnam Emerges As Apple’s Next Destination In The Race For Ai-powered Home Devices
HANOI, Oct 16 (Bernama-VNA) -- Apple is taking an unprecedented step by choosing Vietnam as the main production base for an entirely new product category – ranging from AI-integrated home security cameras and smart home control displays to...

Vietnam promotes tourism at ITB Asia 2025 in Singapore
Singapore (VNA) – Vietnamese tourism businesses are actively promoting the country’s destinations at ITB Asia 2025, alongside MICE Show Asia and Travel Tech Asia, in Singapore from October 15 to 17. Representatives from the Ho Chi Minh City...